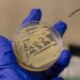

Компания разместила Seres Group акции по верхней границе ценового диапазона и воспользовалась опционом на увеличение объема размещения.
Базирующаяся в Чунцине компания, являющаяся партнером Huawei Technologies Co. в сфере электромобилей, продала около 108,6 млн акций по цене 131,50 гонконгского доллара за акцию, говорится в заявлении, опубликованном в воскресенье. Это включает дополнительные 8,4 млн акций, что увеличило объем размещения примерно на 8,4%.
Цена размещения отражает дисконт в 22% к цене закрытия 155,19 юаня в Шанхае в пятницу, где акции Seres уже торгуются.
Торги акциями Seres в Гонконге начнутся в среду. Эта сделка стала восьмым листингом в Гонконге в этом году, привлекшим более $1 млрд. Общий объем привлеченных средств на гонконгской бирже уже превысил $26 млрд, что выше прогноза Bloomberg Intelligence на 2025 год.
Основанная в 1986 году, компания изначально производила пружины и амортизаторы, затем расширила деятельность до мотоциклов, а позже — до электромобилей. Партнерство с Huawei стало важным фактором успеха Seres: по оценкам аналитиков, собранным Bloomberg, прибыль компании в этом году может вырости на 72%, достигнув рекордных 10,2 млрд юаней.
Совместными организаторами размещения Seres выступили China International Capital Corp. и China Galaxy Securities Co.